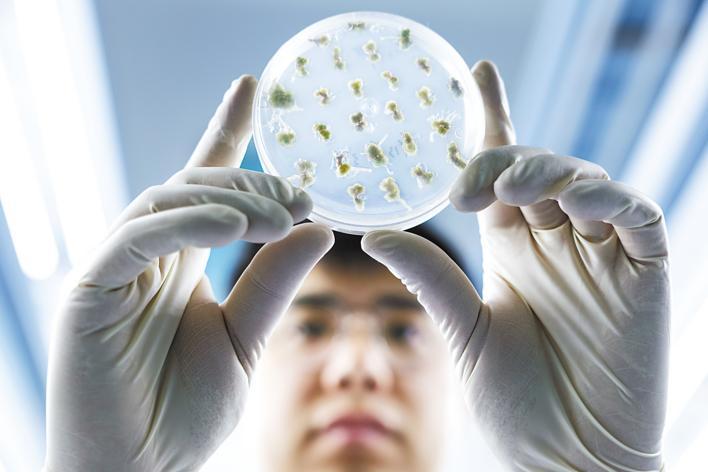

3月19日,在中国农科院油料所武昌基地油菜试验田里,科研助理聂君伟(左)和研究生杜启(右)正在采集油菜样本。

3月20日,在中国农科院油料所阳逻基地千亩油菜试验田内,油菜遗传育种助理研究员王会正在对油菜花朵套袋,以保证油菜育种的纯度。

3月18日,在中国农科院油料所植物工厂内,科研助理匡列琼(右一)和同事田泽(右二)、胡小晗(左一)、余坦(左二)正在定期维护油菜植株,并观察记录。

3月19日,在中国农科院油料所实验室内,油料作物分子改良方向科研助理刘婧琳在无菌操作台上进行油菜遗传转化操作。

3月18日,在中国农科院油料所的智能人工气候室内,油菜抗逆方向研究生李一林正在对油菜植株进行杂交操作。
3月19日,油料分子改良方向科研助理张亮在组培生长间内观察油菜愈伤组织生长情况。

3月18日,种质资源助理研究员李浩在油料所的油料种子库内挑选油菜种子样本。
图湖北日报全媒记者 任勇
文湖北日报全媒记者 汪彤 通讯员 张惠雯 张杨
春来无事,只为花忙。
3月19日,武汉市武昌区徐东二路,隶属于中国农业科学院油料作物研究所(简称油料所)武昌基地的试验田里,一簇簇、一朵朵金灿灿的油菜花肆意怒放、随风舞动,美如童话。
科研人员们却无暇欣赏美景。油菜花期也是杂交授粉的关键期,他们每天“泡”在花田中,观察记录、选择单株、挂牌套袋,忙碌不已。
粮安天下,种铸基石。为端稳国人“油瓶子” 他们只争朝夕育良种。
2022年至2024年,中央一号文件连续三年对提高油料产能提出明确要求。作为我国第一大油料作物的油菜,被寄予厚望。加快选育高油、高产、高抗的油菜新品种,成为保障国家粮油安全、促进油料生产的当务之急、关键之举。
成立于1960年的油料所,是我国唯一的国家级油料专业研究机构。依托该所管理、运行的国家油料作物种质资源中期库(武汉),储存着油菜、花生、芝麻、向日葵、蓖麻、红花、苏子等油料种子,共计4.43万份,是目前全球最大、保存油料作物种质资源数量最多、种类最齐的种质资源库。
依托这些珍贵的种质资源,科研人员通过杂交、基因编辑等技术手段,将高产、高油、抗病、抗逆等多个优良基因“转移”到一个品种身上,再经过稳定遗传性状,得到“理想型”油菜。
为了加速育种进程,每年5月,他们在长江流域等我国冬油菜产区收获完一批育种材料后,又马不停蹄地赶到青海、甘肃等春油菜产区作杂交测配。一年四季,像呵护自己孩子一样,悉心照料每份试验材料。
近年来,随着一系列育种新技术、新装备采用,育种创新逐渐变成一种相对可控、可预期的过程。
湖北日报全媒记者在该所智能人工气候室看到,一株株处于不同生长阶段的油菜被笼罩在紫红色的光中。据介绍,这种特殊的光是由油菜生长所需的红橙光和蓝紫光合成,可以实现光强动态调节,突破季节限制,让油菜一年四季都能生长,实现育种快速加代。
一些新鲜的油菜花蕾将被送往该所小孢子培养实验室。只见科研人员从恒温箱中拿出一个培养皿,底部沉淀着一层薄薄的黄绿色花粉,将其放到电子显微镜下,连接的电脑屏幕上瞬间出现小孢子的放大图像。据介绍,这是该所历时二十余年,研发的“油菜小孢子培养技术”,将油菜育种时长从过去的至少五年压缩至一年,已成为油菜育种中效率最高的技术之一。
室外生机勃勃,室内只争朝夕。
花谢之后,便是菜籽渐黄。他们期待,今年油菜丰收季,又有新的收获。